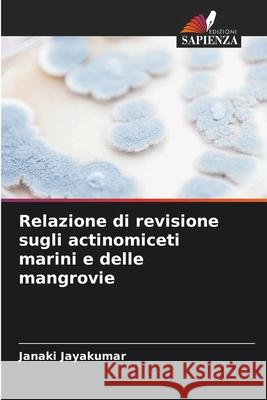
Relazione di revisione sugli actinomiceti marini e delle mangrovie Jayakumar, Janaki 9786208756215 Edizioni Sapienza - książka

Relazione di revisione sugli actinomiceti marini e delle mangrovie » książka
topmenu
Relazione di revisione sugli actinomiceti marini e delle mangrovie
ISBN-13: 9786208756215 / Włoski / Miękka / 2025 / 76 str.
Kategorie BISAC:
Wydawca:
Edizioni Sapienza
Język:
Włoski
ISBN-13:
9786208756215
Rok wydania:
2025
Ilość stron:
76
Wymiary:
22.0 x 15.0
Oprawa:
Miękka